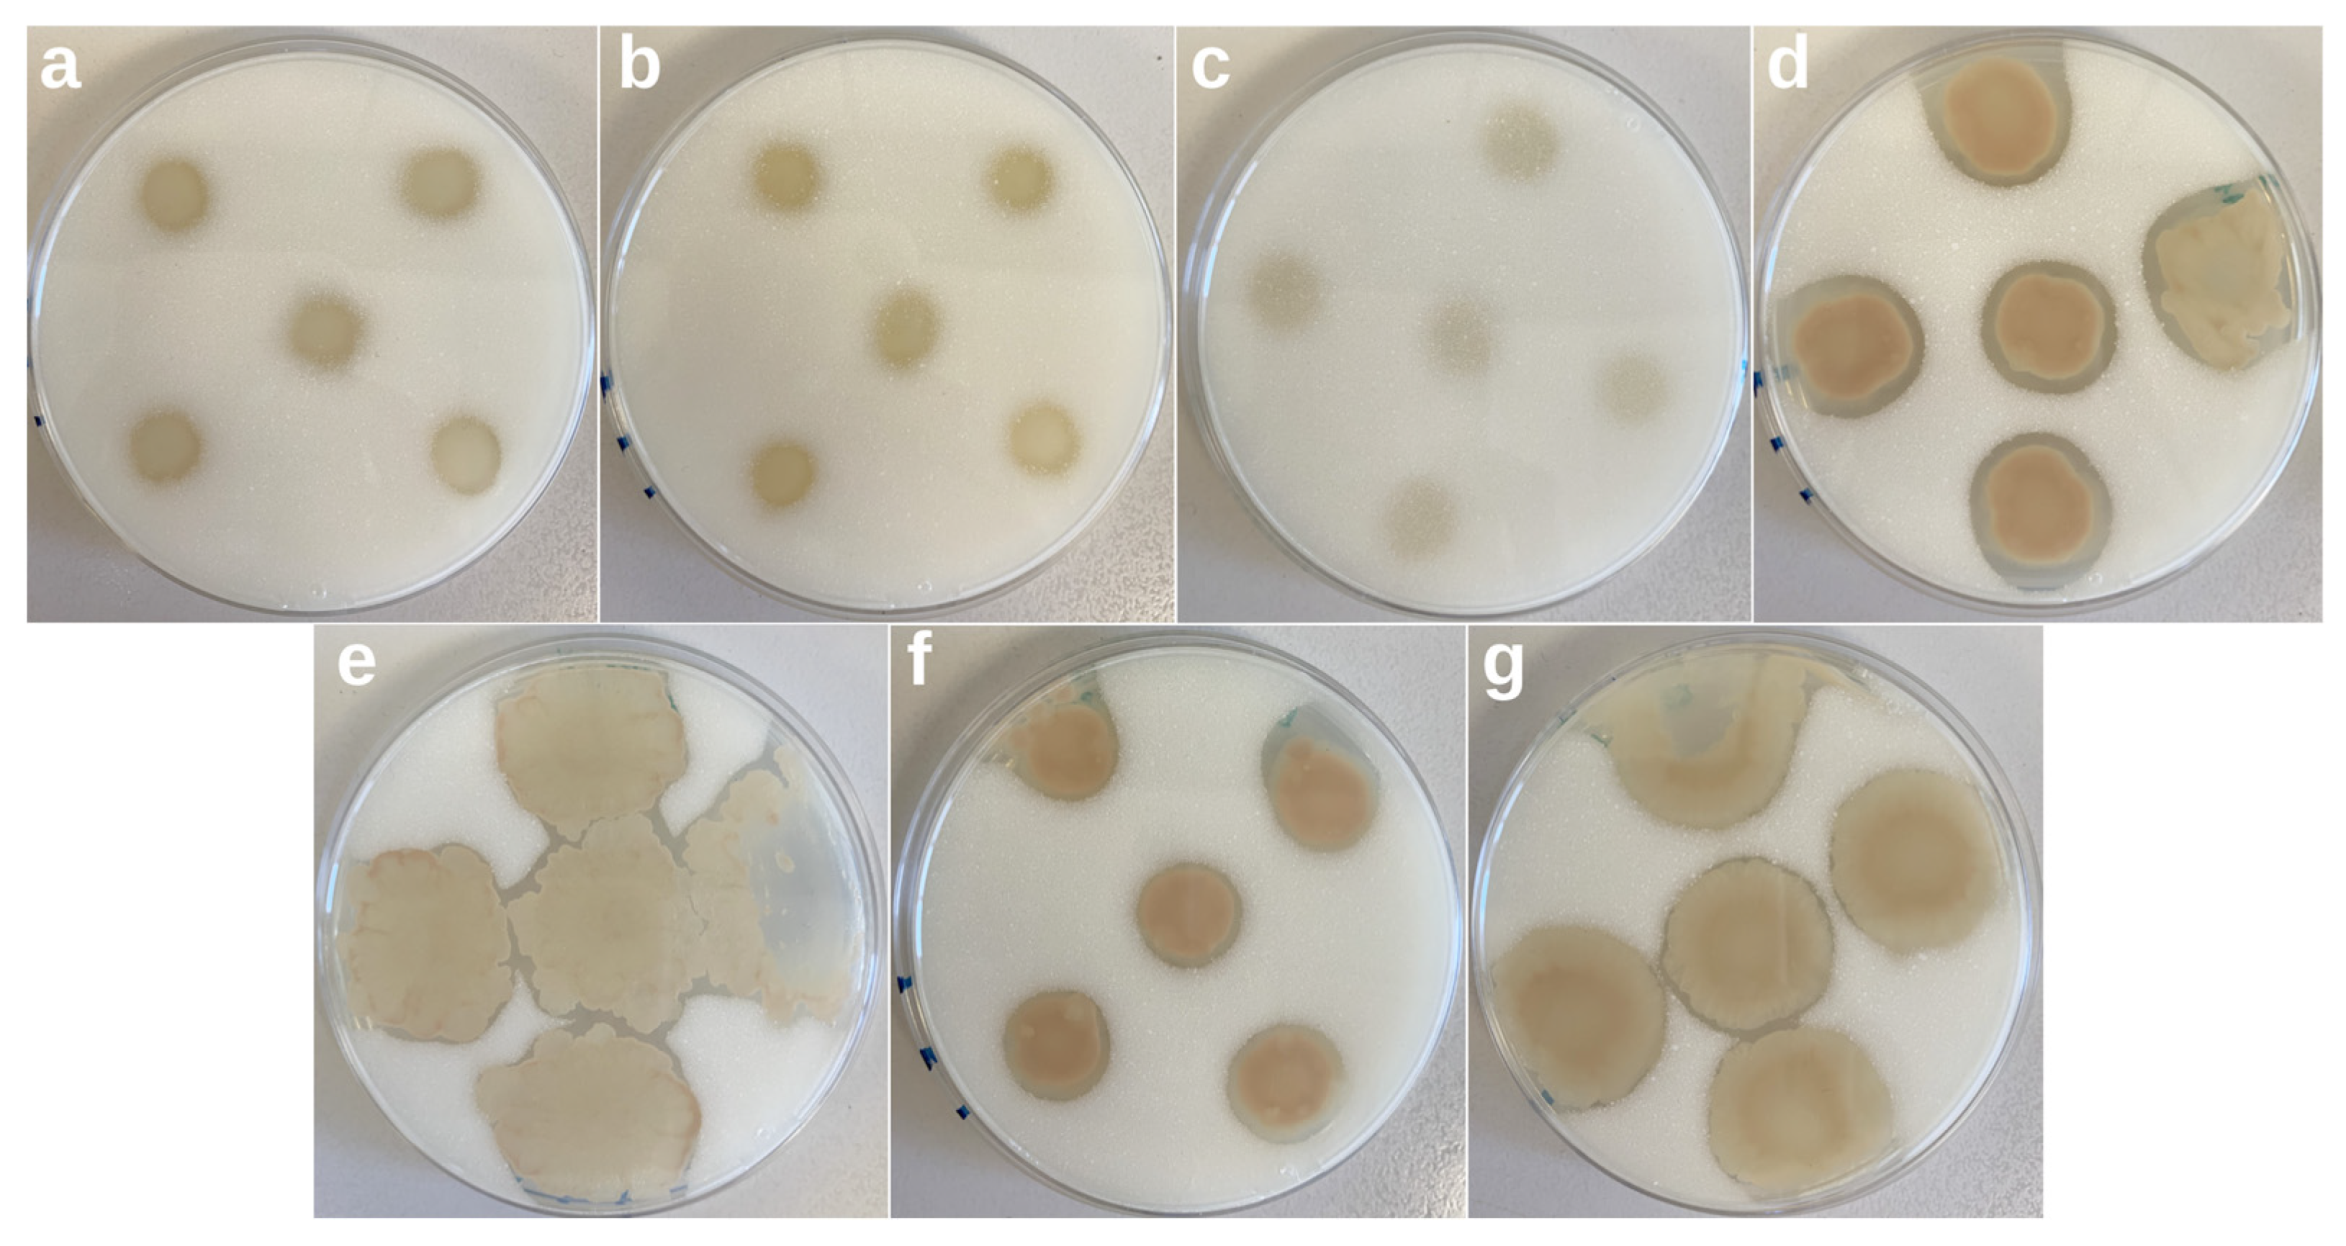

Microbiological Characterization of the Biofilms Colonizing Bioplastics in Natural Marine Conditions: A Comparison between PHBV and PLA
Abstract
1. Introduction
2. Materials and Methods
2.1. Materials
2.2. Experimental Setup
2.3. Analysis of Biofilms by Scanning Electron Microscopy (SEM)
2.4. Quantification of Microbial Colonization and Dynamics
2.5. Analysis of Biofilm Diversity and Composition by Amplicon Sequencing
2.5.1. Amplicon Library Preparation and Sequencing
2.5.2. Sequence Processing and Analysis
2.6. Screening of Biopolymer Degraders
2.7. Molecular Identification of Biopolymer Degraders
2.8. Statistical Analysis
3. Results and Discussion
3.1. Analysis of Biofilms by SEM
3.2. Quantification of Microbial Colonization and Dynamics
3.3. Analysis of Biofilm Diversity and Composition by Amplicon Sequencing
3.4. Inference of PLA and PHBV Biofilms’ Metagenomes
3.5. Screening of Biopolymer Degraders
3.6. Molecular Identification of Biopolymer Degraders
4. Conclusions
Supplementary Materials
Author Contributions
Funding
Data Availability Statement
Acknowledgments
Conflicts of Interest
Appendix A
References
- Jambeck, J.; Geyer, R.; Wilcox, C.; Siegler, T.R.; Perryman, M.; Andrady, A.; Narayan, R.; Law, K.L. Plastic waste inputs from land into the ocean. Mar. Pollut. 2015, 347, 768–771. [Google Scholar] [CrossRef] [PubMed]
- Briassoulis, D.; Pikasi, A.; Briassoulis, C.; Mistriotis, A. Disintegration behaviour of bio-based plastics in coastal zone marine environments: A field experiment under natural conditions. Sci. Total Environ. 2019, 688, 208–223. [Google Scholar] [CrossRef] [PubMed]
- Brunner, I.; Fischer, M.; Rüthi, J.; Stierli, B.; Frey, B. Ability of fungi isolated from plastic debris floating in the shoreline of a lake to degrade plastics. PLoS ONE 2018, 13, e0202047. [Google Scholar] [CrossRef] [PubMed]
- European, B. Nova-Institute Bioplastics Market Data 2018. Global Production Capacities of Bioplastics 2018–2013. Available online: https://www.european-bioplastics.org/wp-content/uploads/2016/02/Report_Bioplastics-Market-Data_2018.pdf (accessed on 25 May 2023).
- Dilkes-Hoffman, L.S.; Lant, P.A.; Laycock, B.; Pratt, S. The rate of biodegradation of PHA bioplastics in the marine environment: A meta-study. Mar. Pollut. Bull. 2019, 142, 15–24. [Google Scholar] [CrossRef]
- European, B. Nova-Institute Bioplastics Market Update 2020. Available online: https://www.european-bioplastics.org/market-update-2020-bioplastics-continue-to-become-mainstream-as-the-global-bioplastics-market-is-set-to-grow-by-36-percent-over-the-next-5-years/ (accessed on 25 May 2023).
- Meereboer, K.W.; Misra, M.; Mohanty, A.K. Review of recent advances in the biodegradability of polyhydroxyalkanoate (PHA) bioplastics and their composites. Green Chem. 2020, 22, 5519–5558. [Google Scholar] [CrossRef]
- Deroiné, M.; César, G.; Le Duigou, A.; Davies, P.; Bruzaud, S. Natural Degradation and Biodegradation of Poly(3-Hydroxybutyrate-co-3-Hydroxyvalerate) in Liquid and Solid Marine Environments. J. Polym. Environ. 2015, 23, 493–505. [Google Scholar] [CrossRef]
- Karamanlioglu, M.; Preziosi, R.; Robson, G.D. Abiotic and biotic environmental degradation of the bioplastic polymer poly(lactic acid): A review. Polym. Degrad. Stab. 2017, 137, 122–130. [Google Scholar] [CrossRef]
- Singha, S.; Hedenqvist, M.S. A review on barrier properties of poly(lactic Acid)/clay nanocomposites. Polymers 2020, 12, 1095. [Google Scholar] [CrossRef]
- Marano, S.; Laudadio, E.; Minnelli, C.; Stipa, P. Tailoring the Barrier Properties of PLA: A State-of-the-Art Review for Food Packaging Applications. Polymers 2022, 14, 1626. [Google Scholar] [CrossRef]
- Melendez-Rodriguez, B.; Torres-Giner, S.; Angulo, I.; Pardo-Figuerez, M.; Hilliou, L.; Escuin, J.M.; Cabedo, L.; Nevo, Y.; Prieto, C.; Lagaron, J.M. High-oxygen-barrier multilayer films based on polyhydroxyalkanoates and cellulose nanocrystals. Nanomaterials 2021, 11, 1443. [Google Scholar] [CrossRef]
- Sanchez-Safont, E.L.; Gonzalez-Ausejo, J.; Gamez-Perez, J.; Lagaron, J.M.; Cabedo, L. Poly(3-Hydroxybutyrate-co-3-Hydroxyvalerate)/purified cellulose fiber composites by melt blending: Characterization and degradation in composting conditions. J. Renew. Mater. 2016, 4, 123–132. [Google Scholar] [CrossRef]
- Volova, T.G.; Boyandin, A.N.; Vasil’ev, A.D.; Karpov, V.A.; Kozhevnikov, I.V.; Prudnikova, S.V.; Rudnev, V.P.; Xuån, B.B.; Dũng, V.V.; Gitel’zon, I.I. Biodegradation of polyhydroxyalkanoates (PHAs) in the South China Sea and identification of PHA-degrading bacteria. Microbiology 2011, 80, 252–260. [Google Scholar] [CrossRef]
- Nakayama, A.; Yamano, N.; Kawasaki, N. Biodegradation in seawater of aliphatic polyesters. Polym. Degrad. Stab. 2019, 166, 290–299. [Google Scholar] [CrossRef]
- Chamas, A.; Moon, H.; Zheng, J.; Qiu, Y.; Tabassum, T.; Jang, J.H.; Abu-Omar, M.; Scott, S.L.; Suh, S. Degradation Rates of Plastics in the Environment. ACS Sustain. Chem. Eng. 2020, 8, 3494–3511. [Google Scholar] [CrossRef]
- Tsuji, H.; Suzuyoshi, K. Environmental degradation of biodegradable polyesters 2. Poly(ε-caprolactone), poly[(R)-3-hydroxybutyrate], and poly(L-lactide) films in natural dynamic seawater. Polym. Degrad. Stab. 2002, 75, 357–365. [Google Scholar] [CrossRef]
- Tsuji, H.; Suzuyoshi, K. Environmental degradation of biodegradable polyesters and poly (L-lactide) films in controlled static seawater. Polym. Degrad. Stab. 2002, 75, 347–355. [Google Scholar] [CrossRef]
- Pinto, M.; Langer, T.M.; Hüffer, T.; Hofmann, T.; Herndl, G.J. The composition of bacterial communities associated with plastic biofilms differs between different polymers and stages of biofilm succession. PLoS ONE 2019, 14, e0217165. [Google Scholar] [CrossRef]
- Veses, V.; González-Torres, P.; Carbonetto, B.; Jovani-Sancho, M.D.M.; González-Martínez, R.; Cortell-Ballester, I.; Sheth, C.C. Dental black plaque: Metagenomic characterization and comparative analysis with white-plaque. Sci. Rep. 2020, 10, 15962. [Google Scholar] [CrossRef]
- Boylen, E.; Rideout, J.R.; Dillon, M.R. Reproducible, interactive, scalable and extensible microbiome data science using QIIME 2. Nat. Biotechnol. 2019, 37, 852–857. [Google Scholar] [CrossRef]
- Callahan, B.J.; McMurdie, P.J.; Rosen, M.J.; Han, A.W.; Johnson, A.J.A.; Holmes, S.P. DADA2: High-resolution sample inference from Illumina amplicon data. Nat. Methods 2016, 13, 581–583. [Google Scholar] [CrossRef]
- Lozupone, C.; Lladser, M.E.; Knights, D.; Stombaugh, J.; Knight, R. UniFrac: An effective distance metric for microbial community comparison. ISME J. 2011, 5, 169–172. [Google Scholar] [CrossRef]
- Venn Diagram Plotter Tool. Available online: https://bioinformatics.psb.ugent.be/webtools/Venn/ (accessed on 25 May 2023).
- Morohoshi, T.; Ogata, K.; Okura, T.; Sato, S. Molecular characterization of the bacterial community in biofilms for degradation of poly(3-hydroxybutyrate-co-3-hydroxyhexanoate) films in seawater. Microbes Environ. 2018, 33, 19–25. [Google Scholar] [CrossRef] [PubMed]
- Volova, T.G.; Prudnikova, S.V.; Vinogradova, O.N.; Syrvacheva, D.A.; Shishatskaya, E.I. Microbial Degradation of Polyhydroxyalkanoates with Different Chemical Compositions and Their Biodegradability. Microb. Ecol. 2017, 73, 353–367. [Google Scholar] [CrossRef]
- ASTM D6691-17; Standard Test Method for Determining Aerobic Biodegradation of Plastic Materials in the Marine Environment by a Defined Microbial Consortium or Natural Sea Water Inoculum. ASTM: West Conshohocken, PA, USA, 2017.
- Delacuvellerie, A.; Cyriaque, V.; Gobert, S.; Benali, S.; Wattiez, R. The plastisphere in marine ecosystem hosts potential specific microbial degraders including Alcanivorax borkumensis as a key player for the low-density polyethylene degradation. J. Hazard. Mater. 2019, 380, 120899. [Google Scholar] [CrossRef] [PubMed]
- Cafaro, V.; Izzo, V.; Notomista, E.; Di Donato, A. Marine Hydrocarbonoclastic Bacteria; Woodhead Publishing Limited: Sawston, UK, 2013; ISBN 9781907568800. [Google Scholar]
- Lane, D.J. 16S/23S rRNA Sequencing. In Nucleic Acid Techniques in Bacterial Systematic; Stackebrandt, E., Goodfellow, M., Eds.; John Wiley and Sons: New York, NY, USA, 1995; pp. 115–175. [Google Scholar]
- Sosa, A.; Chen, F. An In Situ Study to Understand Community Structure of Estuarine Microbes on the Plastisphere. Microorganisms 2022, 10, 1543. [Google Scholar] [CrossRef] [PubMed]
- Salta, M.; Wharton, J.A.; Blache, Y.; Stokes, K.R.; Briand, J.F. Marine biofilms on artificial surfaces: Structure and dynamics. Environ. Microbiol. 2013, 15, 2879–2893. [Google Scholar] [CrossRef]
- Ramsperger, A.F.R.M.; Stellwag, A.C.; Caspari, A.; Fery, A.; Lueders, T.; Kress, H.; Löder, M.G.J.; Laforsch, C. Structural diversity in early-stage biofilm formation on microplastics depends on environmental medium and polymer properties. Water 2020, 12, 3216. [Google Scholar] [CrossRef]
- Shi, X.; Chen, Z.; Wei, W.; Chen, J.; Ni, B.-J. Toxicity of micro/nanoplastics in the environment: Roles of plastisphere and eco-corona. Soil Environ. Health 2023, 1, 100002. [Google Scholar] [CrossRef]
- Feng, L.; He, L.; Jiang, S.; Chen, J.; Zhou, C.; Qian, Z.J.; Hong, P.; Sun, S.; Li, C. Investigating the composition and distribution of microplastics surface biofilms in coral areas. Chemosphere 2020, 252, 126565. [Google Scholar] [CrossRef]
- Bryant, J.A.; Clemente, T.M.; Viviani, D.A.; Fong, A.A.; Thomas, K.A.; Kemp, P.; Karl, D.M.; White, A.E.; DeLong, E.F. Diversity and Activity of Communities Inhabiting Plastic Debris in the North Pacific Gyre. MSystems 2016, 1, e00024-16. [Google Scholar] [CrossRef]
- Reisser, J.; Shaw, J.; Hallegraeff, G.; Proietti, M.; Barnes, D.K.A.; Thums, M.; Wilcox, C.; Hardesty, B.D.; Pattiaratchi, C. Millimeter-sized marine plastics: A new pelagic habitat for microorganisms and invertebrates. PLoS ONE 2014, 9, e100289. [Google Scholar] [CrossRef] [PubMed]
- Du, Y.; Liu, X.; Dong, X.; Yin, Z. A review on marine plastisphere: Biodiversity, formation, and role in degradation. Comput. Struct. Biotechnol. J. 2022, 20, 975–988. [Google Scholar] [CrossRef] [PubMed]
- Esensoy, F.B.; Şentürk, Y.; Aytan, Ü. Microbial biofilm on plastics in the southeastern Black Sea. In Marine Litter in Black Sea; Ülgen, A., Pogojeva, M., Simeonova, A., Eds.; Turkish Marine Research Foundation: Istanbul, Turkey, 2020; pp. 268–285. ISBN 978-975-8825-48-6. [Google Scholar]
- Hoagland, K.D.; Rosowski, J.R.; Gretz, M.R.; Roemer, S.C. Diatom extracellular polymeric substances: Function, fine structure, chemistry and physiology. J. Phycol. 1993, 29, 537–566. [Google Scholar] [CrossRef]
- Zhang, B.; Yang, X.; Liu, L.; Chen, L.; Teng, J.; Zhu, X.; Zhao, J.; Wang, Q. Spatial and seasonal variations in biofilm formation on microplastics in coastal waters. Sci. Total Environ. 2021, 770, 145303. [Google Scholar] [CrossRef]
- Masó, M.; Fortuño, J.-M.; de Juan, S.; Demestre, M. Microfouling communities from pelagic and benthic marine plastic debris sampled across Mediterranean coastal waters. In Scientia Marina; Pelegrí, J.L., Vaqué, D., Eds.; Institut de Ciències del Mar, CSIC: Barcelona, Spain, 2016; Volume 80, pp. 117–127. [Google Scholar]
- Leadbeater, B.S.C. The Choanoflagellates: Evolution, Biology and Ecology; Cambridge University Press: Cambridge, UK, 2015; ISBN 978-0521884440. [Google Scholar]
- Zettler, E.R.; Mincer, T.J.; Amaral-Zettler, L.A. Life in the “plastisphere”: Microbial communities on plastic marine debris. Environ. Sci. Technol. 2013, 47, 7137–7146. [Google Scholar] [CrossRef]
- Zhi Xiang, J.K.; Bairoliya, S.; Cho, Z.T.; Cao, B. Plastic-microbe interaction in the marine environment: Research methods and opportunities. Environ. Int. 2023, 171, 107716. [Google Scholar] [CrossRef]
- Jacquin, J.; Callac, N.; Cheng, J.; Giraud, C.; Gorand, Y.; Denoual, C.; Pujo-Pay, M.; Conan, P.; Meistertzheim, A.L.; Barbe, V.; et al. Microbial Diversity and Activity During the Biodegradation in Seawater of Various Substitutes to Conventional Plastic Cotton Swab Sticks. Front. Microbiol. 2021, 12, 604395. [Google Scholar] [CrossRef]
- Dussud, C.; Hudec, C.; George, M.; Fabre, P.; Higgs, P.; Bruzaud, S.; Delort, A.M.; Eyheraguibel, B.; Meistertzheim, A.L.; Jacquin, J.; et al. Colonization of non-biodegradable and biodegradable plastics by marine microorganisms. Front. Microbiol. 2018, 9, 1571. [Google Scholar] [CrossRef]
- Tourova, T.; Sokolova, D.; Nazina, T.; Grouzdev, D.; Kurshev, E.; Laptev, A. Biodiversity of microorganisms colonizing the surface of polystyrene samples exposed to different aqueous environments. Sustainability 2020, 12, 3624. [Google Scholar] [CrossRef]
- Roager, L.; Sonnenschein, E.C. Bacterial Candidates for Colonization and Degradation of Marine Plastic Debris. Environ. Sci. Technol. 2019, 53, 11636–11643. [Google Scholar] [CrossRef]
- Frère, L.; Maignien, L.; Chalopin, M.; Huvet, A.; Rinnert, E.; Morrison, H.; Kerninon, S.; Cassone, A.L.; Lambert, C.; Reveillaud, J.; et al. Microplastic bacterial communities in the Bay of Brest: Influence of polymer type and size. Environ. Pollut. 2018, 242, 614–625. [Google Scholar] [CrossRef] [PubMed]
- Kallscheuer, N.; Jogler, M.; Wiegand, S.; Peeters, S.H.; Heuer, A.; Boedeker, C.; Jetten, M.S.M.; Rohde, M.; Jogler, C. Three novel Rubripirellula species isolated from plastic particles submerged in the Baltic Sea and the estuary of the river Warnow in northern Germany. Antonie Van Leeuwenhoek Int. J. Gen. Mol. Microbiol. 2020, 113, 1767–1778. [Google Scholar] [CrossRef] [PubMed]
- Agostini, L.; Moreira, J.C.F.; Bendia, A.G.; Kmit, M.C.P.; Waters, L.G.; Santana, M.F.M.; Sumida, P.Y.G.; Turra, A.; Pellizari, V.H. Deep-sea plastisphere: Long-term colonization by plastic-associated bacterial and archaeal communities in the Southwest Atlantic Ocean. Sci. Total Environ. 2021, 793, 148335. [Google Scholar] [CrossRef]
- Lee, J.W.; Nam, J.H.; Kim, Y.H.; Lee, K.H.; Lee, D.H. Bacterial communities in the initial stage of marine biofilm formation on artificial surfaces. J. Microbiol. 2008, 46, 174–182. [Google Scholar] [CrossRef] [PubMed]
- Kirstein, I.V.; Wichels, A.; Gullans, E.; Krohne, G.; Gerdts, G. The plastisphere–Uncovering tightly attached plastic “specific” microorganisms. PLoS ONE 2019, 14, e0215859. [Google Scholar] [CrossRef] [PubMed]
- Oberbeckmann, S.; Kreikemeyer, B.; Labrenz, M. Environmental factors support the formation of specific bacterial assemblages on microplastics. Front. Microbiol. 2018, 8, 2709. [Google Scholar] [CrossRef]
- Marsay, K.S.; Koucherov, Y.; Davidov, K.; Iankelevich-Kounio, E.; Itzahri, S.; Salmon-Divon, M.; Oren, M. High-resolution screening for marine prokaryotic and eukaryotic taxa with selective preference for PE and PET surfaces. BioRxiv 2022, 1–25. [Google Scholar] [CrossRef]
- Cheng, J.; Jacquin, J.; Conan, P.; Pujo-Pay, M.; Barbe, V.; George, M.; Fabre, P.; Bruzaud, S.; Ter Halle, A.; Meistertzheim, A.L.; et al. Relative Influence of Plastic Debris Size and Shape, Chemical Composition and Phytoplankton-Bacteria Interactions in Driving Seawater Plastisphere Abundance, Diversity and Activity. Front. Microbiol. 2021, 11, 610231. [Google Scholar] [CrossRef]
- Amaral-Zettler, L.A.; Ballerini, T.; Zettler, E.R.; Asbun, A.A.; Adame, A.; Casotti, R.; Dumontet, B.; Donnarumma, V.; Engelmann, J.C.; Frère, L.; et al. Diversity and predicted inter- and intra-domain interactions in the Mediterranean Plastisphere. Environ. Pollut. 2021, 286, 117439. [Google Scholar] [CrossRef]
- Coskun, Ö.K.; Özen, V.; Wankel, S.D.; Orsi, W.D. Quantifying population-specific growth in benthic bacterial communities under low oxygen using H218O. ISME J. 2019, 13, 1546–1559. [Google Scholar] [CrossRef]
- Cleary, D.F.R.; Polónia, A.R.M.; Becking, L.E.; de Voogd, N.J.; Purwanto; Gomes, H.; Gomes, N.C.M. Compositional analysis of bacterial communities in seawater, sediment, and sponges in the Misool coral reef system, Indonesia. Mar. Biodivers. 2018, 48, 1889–1901. [Google Scholar] [CrossRef]
- Blazejak, A.; Schippers, A. High abundance of JS-1- and Chloroflexi-related Bacteria in deeply buried marine sediments revealed by quantitative, real-time PCR. FEMS Microbiol. Ecol. 2010, 72, 198–207. [Google Scholar] [CrossRef]
- Douglas, G.M.; Maffei, V.J.; Zaneveld, J.R.; Yurgel, S.N.; Brown, J.R.; Taylor, C.M.; Huttenhower, C.; Langille, M.G.I. PICRUSt2 for prediction of metagenome functions. Nat. Biotechnol. 2020, 38, 685–688. [Google Scholar] [CrossRef]
- Dimitriou, P.S.; Denesyuk, A.I.; Nakayama, T.; Johnson, M.S.; Denessiouk, K. Distinctive structural motifs co-ordinate the catalytic nucleophile and the residues of the oxyanion hole in the alpha/beta-hydrolase fold enzymes. Protein Sci. 2019, 28, 344–364. [Google Scholar] [CrossRef] [PubMed]
- Oh, C.; Doohun Kim, T.; Kim, K.K. Carboxylic ester hydrolases in bacteria: Active site, structure, function and application. Crystals 2019, 9, 597. [Google Scholar] [CrossRef]
- Sznajder, A.; Pfeiffer, D.; Jendrossek, D. Comparative proteome analysis reveals four novel polyhydroxybutyrate (PHB) granule-associated proteins in Ralstonia eutropha H16. Appl. Environ. Microbiol. 2015, 81, 1847–1858. [Google Scholar] [CrossRef]
- Novackova, I.; Kucera, D.; Porizka, J.; Pernicova, I.; Sedlacek, P.; Koller, M.; Kovalcik, A.; Obruca, S. Adaptation of Cupriavidus necator to levulinic acid for enhanced production of P(3HB-co-3HV) copolyesters. Biochem. Eng. J. 2019, 151, 107350. [Google Scholar] [CrossRef]
- Wang, Q.; Yu, H.; Xia, Y.; Kang, Z.; Qi, Q. Complete PHB mobilization in Escherichia coli enhances the stress tolerance: A potential biotechnological application. Microb. Cell Fact. 2009, 8, 47. [Google Scholar] [CrossRef]
- Cai, G.Q.; Driscoll, B.T.; Charles, T.C. Requirement for the enzymes acetoacetyl coenzyme A synthetase and poly- 3-hydroxybutyrate (PHB) synthase for growth of Sinorhizobium meliloti on PHB cycle intermediates. J. Bacteriol. 2000, 182, 2113–2118. [Google Scholar] [CrossRef] [PubMed]
- Butbunchu, N.; Pathom-Aree, W. Actinobacteria as Promising Candidate for Polylactic Acid Type Bioplastic Degradation. Front. Microbiol. 2019, 10, 2834. [Google Scholar] [CrossRef] [PubMed]
- Huang, B.; Zhang, X.; Wang, C.; Bai, C.; Li, C.; Li, C.; Xin, L. Isolation and characterization of Vibrio harveyi as a major pathogen associated with mass mortalities of ark clam, Scapharca broughtonii, in summer. Aquaculture 2021, 9, 2–17. [Google Scholar] [CrossRef]
- Raghul, S.S.; Bhat, S.G.; Chandrasekaran, M.; Francis, V.; Thachil, E.T. Biodegradation of polyvinyl alcohol-low linear density polyethylene-blended plastic film by consortium of marine benthic vibrios. Int. J. Environ. Sci. Technol. 2014, 11, 1827–1834. [Google Scholar] [CrossRef]
- Oberbeckmann, S.; Osborn, A.M.; Duhaime, M.B. Microbes on a bottle: Substrate, season and geography influence community composition of microbes colonizing marine plastic debris. PLoS ONE 2016, 11, e0159289. [Google Scholar] [CrossRef] [PubMed]
- Li, A.; Luo, H.; Hu, T.; Huang, J.; Alam, N.U.; Meng, Y.; Meng, F.; Korkor, N.L.; Hu, X.; Li, O. Screening and enzymatic activity of high-efficiency gellan lyase producing bacteria Pseudoalteromonas hodoensis PE1. Bioengineered 2019, 10, 240–249. [Google Scholar] [CrossRef]
- Miyazaki, M.; Nogi, Y.; Ohta, Y.; Hatada, Y.; Fujiwara, Y.; Ito, S.; Horikoshi, K. Microbulbifer agarilyticus sp. nov. and Microbulbifer thermotolerans sp. nov., agar-degrading bacteria isolated from deep-sea sediment. Int. J. Syst. Evol. Microbiol. 2008, 58, 1128–1133. [Google Scholar] [CrossRef]
- Park, S.L.; Cho, J.Y.; Kim, S.H.; Bhatia, S.K.; Gurav, R.; Park, S.; Park, K.; Yang, Y. Isolation of Microbulbider sp. SOL66 with High Polyhydroxyalkanoate-Degrading Activity from the Marine Environment. Polymers 2021, 13, 4257. [Google Scholar] [CrossRef]
- Li, Z.; Wei, R.; Gao, M.; Ren, Y.; Yu, B.; Nie, K.; Xu, H.; Liu, L. Biodegradation of low-density polyethylene by Microbulbifer hydrolyticus IRE-31. J. Environ. Manag. 2020, 263, 110402. [Google Scholar] [CrossRef]
- Kim, J.; Kim, D.Y.; Yang, K.H.; Kim, S.; Lee, S.S. Ruegeria lutea sp. Nov., isolated from marine sediment, Masan Bay, South Korea. Int. J. Syst. Evol. Microbiol. 2019, 69, 2854–2861. [Google Scholar] [CrossRef]
- Katoh, K.; Standley, D.M. MAFFT Multiple Sequence Alignment Software Version 7: Improvements in Performance and Usability. Mol. Biol. Evol. 2013, 30, 772–780. [Google Scholar] [CrossRef]

| Observed OTUs | Pielou’s Evenness Index | |
|---|---|---|
| PLA | 1231 | 0.93 |
| PHBV | 693 | 0.92 |
| p value | 0.28 | 0.05 |
| COG | Description | Relative Abundance | |
|---|---|---|---|
| PLA | PHBV | ||
| COG0824 | Acyl-CoA thioesterase FadM | 1.42 × 10−3 | 1.50 × 10−3 |
| COG0412 | Dienelactone hydrolase | 6.80 × 10−4 | 7.98 × 10−4 |
| COG2267 | Lysophospholipase, alpha-beta hydrolase superfamily | 6.79 × 10−4 | 7.87 × 10−4 |
| COG1946 | Acyl-CoA thioesterase | 2.14 × 10−4 | 3.01 × 10−4 |
| COG3509 | Poly(3-hydroxybutyrate) depolymerase | 1.40 × 10−4 | 1.73 × 10−4 |
| COG2272 | Carboxylesterase type B | 3.68 × 10−5 | 7.14 × 10−5 |
| COG3320 | Thioester reductase domain of alpha aminoadipate reductase Lys2 and NRPSs | 2.70 × 10−5 | 5.49 × 10−5 |
| COG5496 | Predicted thioesterase | 2.60 × 10−5 | 4.40 × 10−5 |
| COG3545 | Predicted esterase of the alpha/beta hydrolase fold | 2.24 × 10−5 | 3.81 × 10−5 |
| COG3621 | Patatin-like phospholipase/acyl hydrolase | 9.43 × 10−7 | 7.12 × 10−6 |
| COG1647 | Esterase/lipase | 3.35 × 10−5 | 2.91 × 10−5 |
| COG4947 | Esterase/lipase superfamily enzyme | 3.04 × 10−5 | 1.57 × 10−5 |
| COG3884 | Acyl-ACP thioesterase | 2.84 × 10−5 | 2.02 × 10−5 |
| COG3937 | Polyhydroxyalkanoate synthesis regulator phasin A | 7.12 × 10−6 | 8.98 × 10−7 |
| Isolate | Identification | Maximum Identity (%) | NCBI Database (Accession Number) |
|---|---|---|---|
| A11 | Vibrio kanaloae | 100.0 | NR_042468.1 |
| B1 | Pseudoalteromonas hodoensis | 99.9 | NR_126232.1 |
| B9 | Microbulbifer agarilyticus | 99.5 | NR_041001.1 |
| C2 | Ruegeria atlantica | 99.7 | NR_112615.1 |
Disclaimer/Publisher’s Note: The statements, opinions and data contained in all publications are solely those of the individual author(s) and contributor(s) and not of MDPI and/or the editor(s). MDPI and/or the editor(s) disclaim responsibility for any injury to people or property resulting from any ideas, methods, instructions or products referred to in the content. |
© 2023 by the authors. Licensee MDPI, Basel, Switzerland. This article is an open access article distributed under the terms and conditions of the Creative Commons Attribution (CC BY) license (https://creativecommons.org/licenses/by/4.0/).
Share and Cite
Marín, A.; Feijoo, P.; de Llanos, R.; Carbonetto, B.; González-Torres, P.; Tena-Medialdea, J.; García-March, J.R.; Gámez-Pérez, J.; Cabedo, L. Microbiological Characterization of the Biofilms Colonizing Bioplastics in Natural Marine Conditions: A Comparison between PHBV and PLA. Microorganisms 2023, 11, 1461. https://doi.org/10.3390/microorganisms11061461
Marín A, Feijoo P, de Llanos R, Carbonetto B, González-Torres P, Tena-Medialdea J, García-March JR, Gámez-Pérez J, Cabedo L. Microbiological Characterization of the Biofilms Colonizing Bioplastics in Natural Marine Conditions: A Comparison between PHBV and PLA. Microorganisms. 2023; 11(6):1461. https://doi.org/10.3390/microorganisms11061461
Chicago/Turabian StyleMarín, Anna, Patricia Feijoo, Rosa de Llanos, Belén Carbonetto, Pedro González-Torres, José Tena-Medialdea, José R. García-March, José Gámez-Pérez, and Luis Cabedo. 2023. "Microbiological Characterization of the Biofilms Colonizing Bioplastics in Natural Marine Conditions: A Comparison between PHBV and PLA" Microorganisms 11, no. 6: 1461. https://doi.org/10.3390/microorganisms11061461
APA StyleMarín, A., Feijoo, P., de Llanos, R., Carbonetto, B., González-Torres, P., Tena-Medialdea, J., García-March, J. R., Gámez-Pérez, J., & Cabedo, L. (2023). Microbiological Characterization of the Biofilms Colonizing Bioplastics in Natural Marine Conditions: A Comparison between PHBV and PLA. Microorganisms, 11(6), 1461. https://doi.org/10.3390/microorganisms11061461

